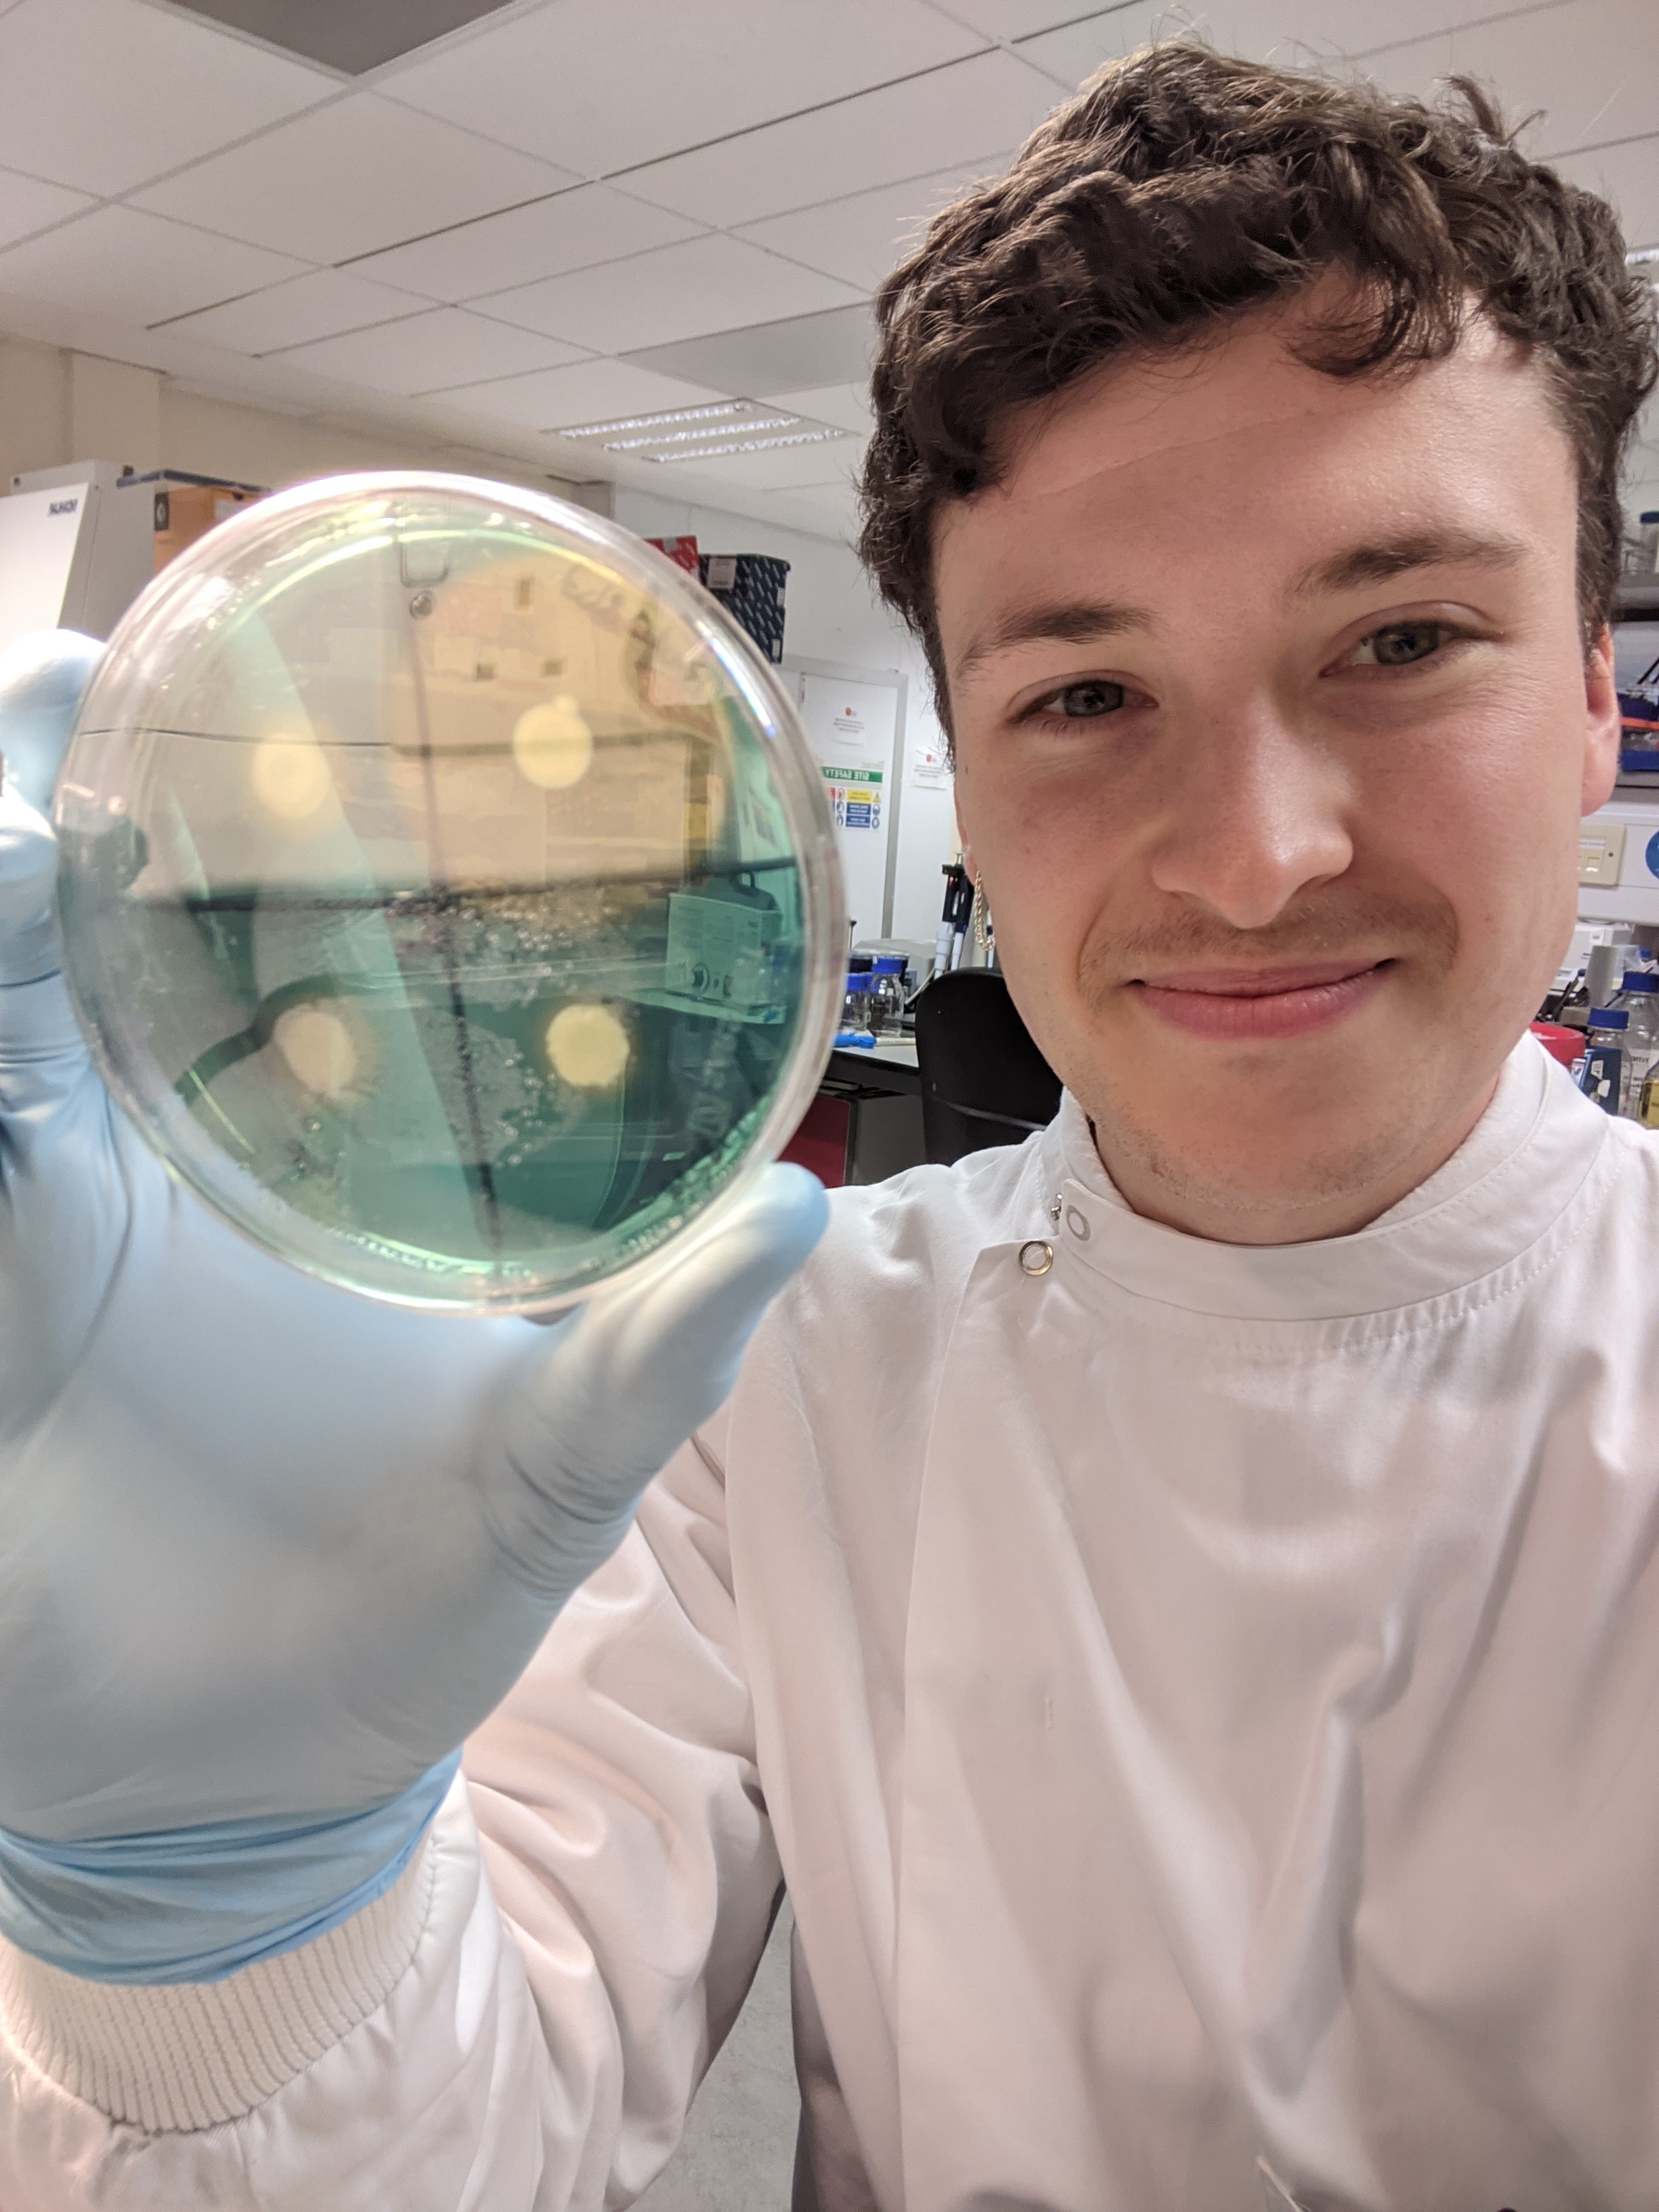

Presenters' biography
| Speaker 1 - Pr Kathryn Holt (London School of Hygiene & Tropical Medicine, London, UK) |
|---|

|
| Kat is a computational biologist specialising in infectious disease genomics. She is Professor of Microbial Systems Genomics, and co-Director of the Antimicrobial Resistance (AMR) Centre, at the London School of Hygiene and Tropical Medicine. Kat holds a BA/BSc, Master of Epidemiology, and PhD in Molecular Biology. Kat and her team are particularly interested in the evolution and spread of AMR, and vaccine design and deployment against AMR pathogens. Two organisms of particular focus are Salmonella Typhi (the agent of typhoid fever), and Klebsiella pneumoniae (a leading cause of neonatal sepsis and healthcare-associated infections globally). To support genomics-informed research and surveillance for these pathogens, Kat’s team have developed organism-specific genomic typing tools (Kleborate and Kaptive for Klebsiella, GenoTyphi for Typhi), and co-founded international collaborative consortia to develop and promote community-driven approaches to bacterial pathogen genomics (KlebNET, the Global Typhoid Genomics Consortium, and the ESGEM-AMR Working Group). |
| Speaker 2 - Pr Sylvain Brisse (Institut Pasteur, France) |
|---|

| | I combine public health surveillance and research activities. My lab is in charge of the microbiological surveillance of diphtheria and pertussis (whooping cough) under mandates of the French Public Health Agency (Santé publique France); we provide diagnostics, expertise, and clinical advice. Our research focuses on the microbial population biology and emergence of pathogenic microbial strains, vaccine escape, and antimicrobial resistance. We also develop applications in diagnostics and public health, including universal strain subtype genotyping systems and nomenclatures that facilitate international epidemiological tracking and micro-evolutionary studies |
| Speaker 3 - Dr Tom Stanton (Monash University, Melbourne, Australia) |
|---|

|
| Tom is a computational microbiologist with a background in clinical and molecular microbiology. He is a Research Fellow in the Wyres Lab at the Department of Infectious Diseases, Monash University. Tom completed a BSc (Hons) in Biomedical Science, then worked on AMR surveillance and developing pathogen genomics at UKHSA in London, before completing a PhD at the University of Edinburgh (UK), characterising resistance mechanisms to a novel antibiotic in K. pneumoniae and A. baumannii. After finding an affinity for bacterial genomics during lockdown, Tom joined the Holt Lab at LSHTM working on K. pneumoniae sero-epidemiology and developing the in silico serotyping tool, Kaptive, which is now his primary research focus. |
| Speaker 4 - Dr Margaret Lam (Monash University, Melbourne, Australia) |
|---|

| | Margaret is an NHMRC Emerging Leadership Fellow and Co-lead of the Infectious Diseases Genomics program at the Department of Infectious Diseases, Monash University. Her research largely focuses on using computational biology and comparative genomics to investigate the genetic diversity and distribution of mobile elements like plasmids that often carry antimicrobial resistance or virulence genes, in bacterial pathogens like Klebsiella pneumoniae and Acinetobacter baumannii. Margaret completed a Bachelor in Biomedical Science, Honours in Science and a Doctoral degree at The University of Melbourne. |
| Speaker 5 - Pr Kelly Wyres (Monash University, Melbourne, Australia) |
|---|

| | Kelly is a computational microbiologist with a background in bacterial population genetics and genomics. She is Associate Professor, Research Group Leader and Co-Lead for the Infectious Diseases Genomics program at the Department of Infectious Diseases, Monash University. Kelly's work focuses primarily on Klebsiella pneumoniae; in particular diversity of surface antigens (targets for novel anti-Klebsiella vaccines and phage therapies), as well as the features, evolution and metabolism of closely related groups of K. pneumoniae, called ‘clones,’ that are associated with distinct behaviours and clinical risks. Kelly completed a Bachelor's degree in Biological Sciences and a doctoral (DPhil) degree in Zoology (bacterial genomics) from the University of Oxford, UK, after which she spent some time in an industry role at IBM Research - Australia before returning to an academic role at the University of Melbourne, and now Monash University. |
|
| Speaker 6 - Ms Marit Hetland (Stavanger University, Stavanger, Norway) |
|---|

| | Marit is a computational biologist specialising in bacterial population genomics and tool development for genomic analyses. She is a bioinformatician at the Department of Medical Microbiology, Stavanger University Hospital, and a PhD candidate in Microbial Genomics at the Department of Biological Sciences, University of Bergen. Her research focuses primarily on the genomic epidemiology of Klebsiella pneumoniae, including studies within a One Health framework that explore interactions between human, animal, and environmental reservoirs. She also contributes to the Norwegian National Reference Laboratory for Legionella, where she develops tools for genomic characterisation and surveillance. |
| Speakers 7, 8 and 9 - Dr Erik Alm, Dr Marius Linkevicius and Dr Anke Kohlenberg (European Centre for Disease Prevention and Control, Stockholm, Sweden) |
|---|
| | | Erik, Marius and Anke support European Antimicrobial Resistance Genes Surveillance Network (EURGen-Net) at the European Centre for Diseases Prevention and Control (ECDC). EURGen-Net is a genomic-based surveillance network for multidrug-resistant bacteria of public health importance, including Klebsiella pneumoniae. Erik contributes with expertise in bioinformatics and genomic analysis. Marius brings a microbiological perspective with a focus on antimicrobial resistance. Anke provides experience in healthcare-associated infections, clinical microbiology, and public health epidemiology. Together, and in collaboration with other colleagues, they coordinate structured European surveys and support cross-border outbreak investigations of carbapenem-resistant Enterobacterales. |
Last modified: Tuesday, 2 September 2025, 8:50 AM